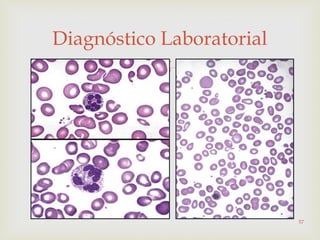

Diagnóstico Laboratorial
57
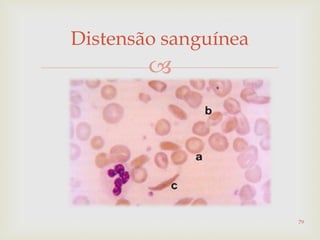

Distensão sanguínea
79
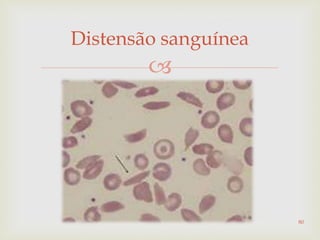

Distensão sanguínea
80
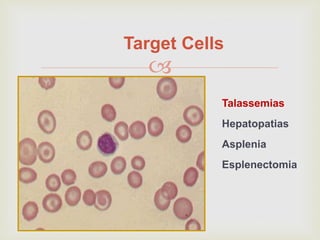

Target Cells
Talassemias
Hepatopatias
Asplenia
Esplenectomia
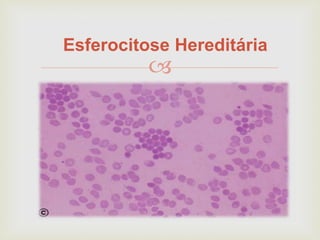

Esferocitose Hereditária

Este documento discute vários tipos de anemias, incluindo suas causas, sintomas e abordagens de diagnóstico. Ele fornece detalhes sobre a eritropoese normal e anormal, anemias microcíticas e hipocrômicas como a anemia ferropênica, anemias macrocíticas como a anemia megaloblástica e a anemia perniciosa.